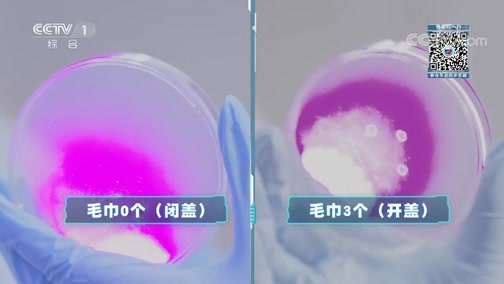

|
管理员

|
来源:央视网
更新时间:2018年09月23日 23:12 视频简介:本期节目主要内容: 高颜值机器人“S man”出道曝内幕,陈鲲羽“躺枪”; 14岁高中生PK中科院生物化学美女博士; 空气也能做“弹药”,大口径空气炮让现场“燃烧”; 400年前经典实验被还原,大气压强威力到底有多大; 汽车落水的正确逃生方式,车中常备安全锤。 (《加油!向未来》第三季 20180923)   《加油!向未来》第三季 20180923 《加油!向未来》第三季 201809232018-09-23 23:12:22 《加油!向未来》第三季 20180909 《加油!向未来》第三季 201809092018-09-09 22:42:43  《加油!向未来》第三季 20180902 《加油!向未来》第三季 201809022018-09-03 00:54:52  《加油!向未来》第三季 20180826 《加油!向未来》第三季 201808262018-08-26 22:31:04  《加油!向未来》第三季 20180812 《加油!向未来》第三季 201808122018-08-12 22:33:28  [加油!向未来]未来人类出行的交通工具会是什么呢? [加油!向未来]未来人类出行的交通工具会是什么呢?2018-09-23 22:04:21  [加油!向未来]在太空中能建造第二个地球吗? [加油!向未来]在太空中能建造第二个地球吗?2018-09-23 22:02:22  [加油!向未来]1对23终极PK 中科院美女博士遗憾落败 [加油!向未来]1对23终极PK 中科院美女博士遗憾落败2018-09-23 21:52:21  [加油!向未来]太拼!强子亲试汽车水下30秒密闭空间逃生 [加油!向未来]太拼!强子亲试汽车水下30秒密闭空间逃生2018-09-23 21:40:22  [加油!向未来]汽车落水的正确逃生方式 车中常备安全锤 [加油!向未来]汽车落水的正确逃生方式 车中常备安全锤2018-09-23 21:40:21 图片:333e.cn_7688.jpg  |

 一键同布到我集网·各家微博
一键同布到我集网·各家微博